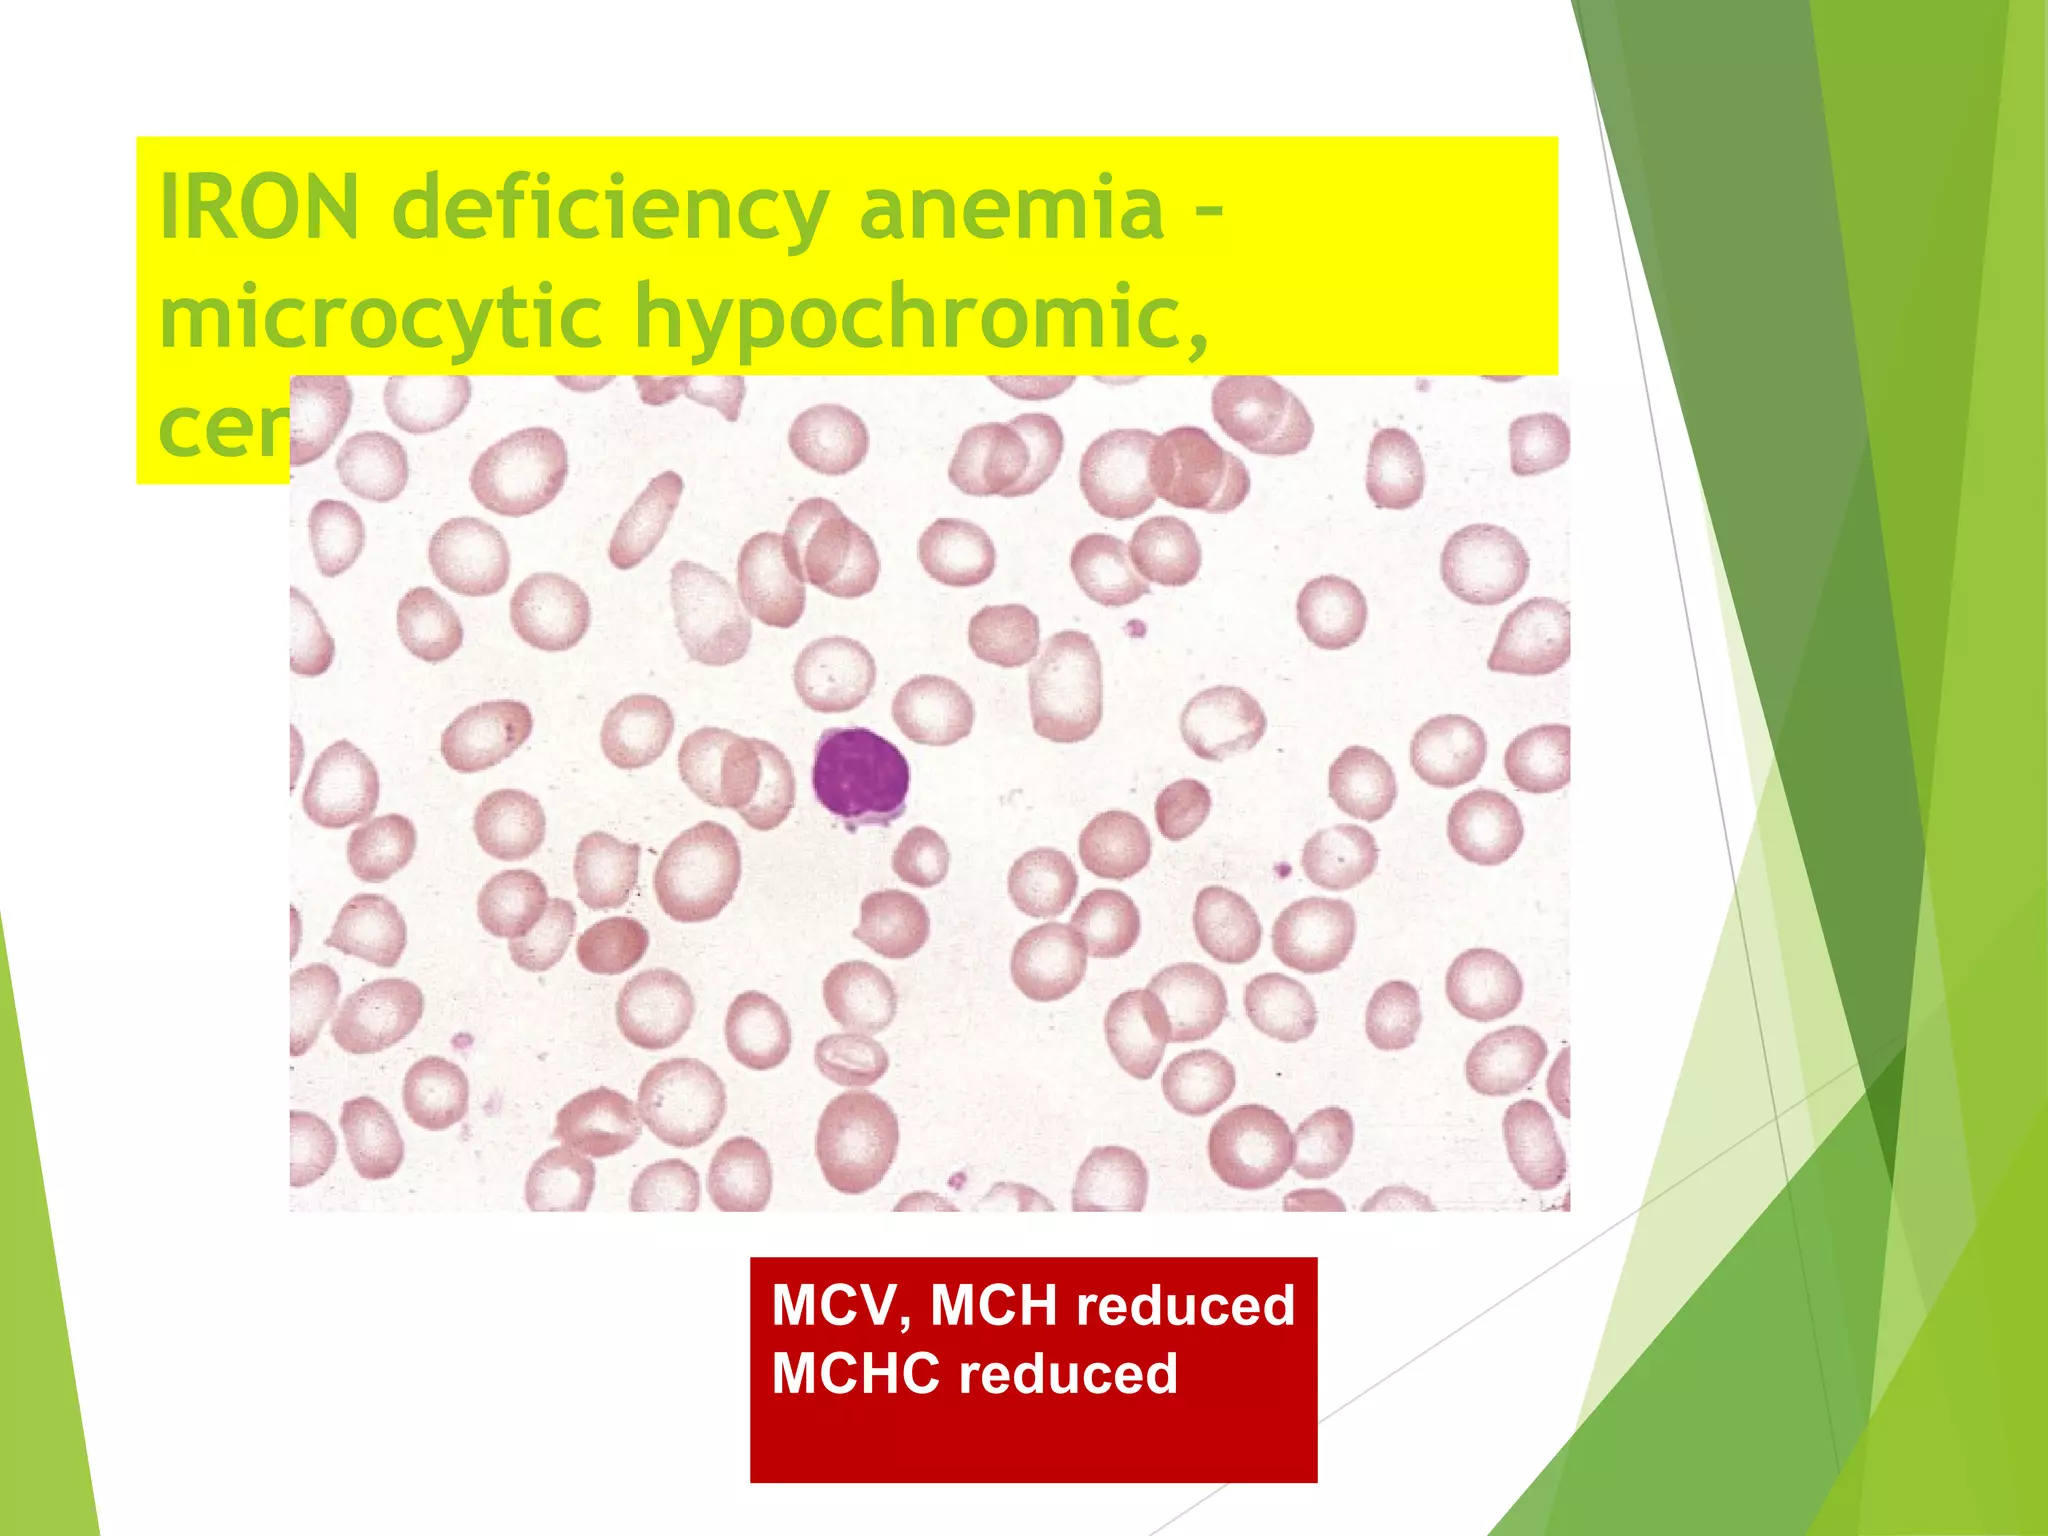
Anemia | PPT

Hypocytic Hypochromic Anemia is a condition characterized by a decrease in the size and hemoglobin content of red blood cells. This type of anemia is often associated with iron deficiency, but it can also result from other underlying conditions. Understanding the causes, symptoms, diagnosis, and treatment of Hypocytic Hypochromic Anemia is crucial for effective management and improved quality of life.
Understanding Hypocytic Hypochromic Anemia
Hypocytic Hypochromic Anemia is a specific type of anemia where the red blood cells are smaller than normal (microcytic) and contain less hemoglobin than usual (hypochromic). This condition is typically identified through blood tests that measure the size and hemoglobin content of red blood cells. The most common cause of Hypocytic Hypochromic Anemia is iron deficiency, but other factors such as chronic diseases, genetic disorders, and certain medications can also contribute to its development.
Causes of Hypocytic Hypochromic Anemia
Several factors can lead to the development of Hypocytic Hypochromic Anemia. The primary causes include:
- Iron Deficiency: This is the most common cause, often resulting from inadequate dietary intake, poor absorption, or chronic blood loss.
- Chronic Diseases: Conditions such as inflammatory bowel disease, chronic kidney disease, and certain cancers can interfere with the body's ability to produce red blood cells.
- Genetic Disorders: Inherited conditions like thalassemia and sickle cell anemia can affect the production and structure of red blood cells.
- Medications: Certain drugs, including some chemotherapy agents and nonsteroidal anti-inflammatory drugs (NSAIDs), can cause Hypocytic Hypochromic Anemia as a side effect.
Symptoms of Hypocytic Hypochromic Anemia
The symptoms of Hypocytic Hypochromic Anemia can vary depending on the severity of the condition. Common symptoms include:
- Fatigue and weakness
- Pale skin
- Shortness of breath
- Dizziness or lightheadedness
- Rapid heartbeat
- Headache
- Cold hands and feet
- Brittle nails and hair loss
In severe cases, individuals may experience more serious symptoms such as chest pain, fainting, and difficulty concentrating. It is essential to seek medical attention if these symptoms persist or worsen.
Diagnosing Hypocytic Hypochromic Anemia
Diagnosing Hypocytic Hypochromic Anemia involves a combination of medical history, physical examination, and laboratory tests. The diagnostic process typically includes:
- Complete Blood Count (CBC): This test measures the size, number, and hemoglobin content of red blood cells. In Hypocytic Hypochromic Anemia, the red blood cells will be smaller and contain less hemoglobin.
- Iron Studies: These tests measure the levels of iron, ferritin, and total iron-binding capacity (TIBC) in the blood. Low levels of iron and ferritin, along with high TIBC, are indicative of iron deficiency.
- Peripheral Blood Smear: This test involves examining a sample of blood under a microscope to assess the shape and size of red blood cells.
- Bone Marrow Biopsy: In some cases, a bone marrow biopsy may be performed to evaluate the production of red blood cells and rule out other underlying conditions.
Additional tests may be ordered based on the initial findings and the suspected cause of the anemia.
Treatment Options for Hypocytic Hypochromic Anemia
The treatment of Hypocytic Hypochromic Anemia depends on the underlying cause. Common treatment options include:
- Iron Supplementation: For iron deficiency anemia, oral iron supplements are often prescribed. These supplements help replenish the body's iron stores and improve red blood cell production.
- Dietary Changes: Increasing the intake of iron-rich foods such as red meat, poultry, fish, beans, and leafy green vegetables can help manage iron deficiency.
- Intramuscular Iron Injections: In severe cases or when oral supplements are not effective, intramuscular iron injections may be administered.
- Treatment of Underlying Conditions: Addressing the underlying cause, such as treating inflammatory bowel disease or managing chronic kidney disease, can help improve anemia.
- Blood Transfusions: In severe cases, blood transfusions may be necessary to quickly increase the red blood cell count and improve oxygen delivery to the body's tissues.
It is important to follow the treatment plan prescribed by a healthcare provider and attend regular follow-up appointments to monitor progress and adjust treatment as needed.
Preventing Hypocytic Hypochromic Anemia
Preventing Hypocytic Hypochromic Anemia involves maintaining a balanced diet and addressing any underlying health conditions. Key preventive measures include:
- Consuming a diet rich in iron, including red meat, poultry, fish, beans, and leafy green vegetables.
- Including vitamin C-rich foods in the diet to enhance iron absorption.
- Avoiding excessive consumption of tea, coffee, and dairy products, which can interfere with iron absorption.
- Regularly screening for and treating underlying conditions that can contribute to anemia.
- Seeking medical attention if symptoms of anemia develop.
By taking these preventive measures, individuals can reduce their risk of developing Hypocytic Hypochromic Anemia and maintain overall health.
📝 Note: Always consult a healthcare provider before making significant changes to your diet or starting any new supplements.
Living with Hypocytic Hypochromic Anemia
Living with Hypocytic Hypochromic Anemia requires ongoing management and monitoring. Individuals with this condition should:
- Follow the treatment plan prescribed by their healthcare provider.
- Attend regular follow-up appointments to monitor blood counts and adjust treatment as needed.
- Maintain a balanced diet rich in iron and other essential nutrients.
- Avoid activities that may exacerbate symptoms, such as strenuous exercise or exposure to extreme temperatures.
- Seek support from healthcare providers, family, and friends to manage the emotional and physical challenges of living with anemia.
With proper management and support, individuals with Hypocytic Hypochromic Anemia can lead active and fulfilling lives.
Complications of Hypocytic Hypochromic Anemia
If left untreated, Hypocytic Hypochromic Anemia can lead to several complications, including:
- Heart problems, such as an enlarged heart or heart failure.
- Growth and development delays in children.
- Pregnancy complications, including preterm birth and low birth weight.
- Increased risk of infections due to a weakened immune system.
- Cognitive impairment and difficulty concentrating.
Regular monitoring and treatment can help prevent these complications and improve overall health outcomes.
Research and Future Directions
Ongoing research is focused on improving the diagnosis and treatment of Hypocytic Hypochromic Anemia. Areas of interest include:
- Developing more accurate and non-invasive diagnostic tools.
- Exploring new treatment options, such as targeted therapies and gene editing.
- Understanding the genetic and environmental factors that contribute to the development of anemia.
- Improving patient education and support to enhance adherence to treatment plans.
Advances in research hold promise for better management and improved quality of life for individuals with Hypocytic Hypochromic Anemia.
Hypocytic Hypochromic Anemia is a complex condition that requires careful management and monitoring. By understanding the causes, symptoms, diagnosis, and treatment options, individuals can take proactive steps to manage their condition and improve their overall health. Regular follow-up with healthcare providers and adherence to treatment plans are essential for effective management and prevention of complications. With ongoing research and advancements in treatment, the future holds promise for better outcomes and improved quality of life for those living with Hypocytic Hypochromic Anemia.
Related Terms:
- microcytic hypochromic anemia labs
- hypochromic anemia
- anisopoikilocytosis
- approach to microcytic hypochromic anemia
- normocytic normochromic anemia
- macrocytic anemia